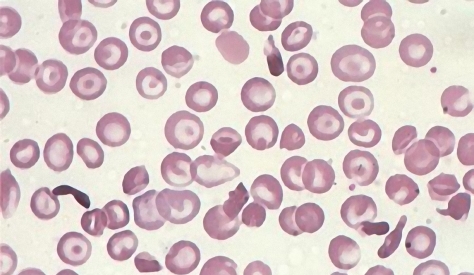
赤血球

妊娠中はとかく貧血になりやすいものです。
日ごろからダイエットにいそしんでいたり、月経時の出血が多かったりして、もともと貧血気味のママは、妊娠初期から貧血になるケースが多いようです。
そうでなくても、妊娠が進むと、貧血になる妊婦さん続出なンですねー(-_-)
どうしてかっていうと、子宮が大きくなると、ママの体内を流れる血液量が急増するから。このとき、液体成分の血漿(けっしょう)は問題なく増えますが、赤血球などの大切な固体成分の生産が追いつきません。それで、血液が薄くなってしまうのです。
さらに赤ちゃんが自分で血液をつくるようになると、ママの身体の鉄分がどんどん持っていかれてしまう。だから、おなかの赤ちゃんの整腸にともない、貧血がひどくなるのです。
血液が薄まると、サラサラして血液循環がよくなり、赤ちゃんに血液がいきわたりやすくなるという利点もあります。でもね。血液量が急激に増える妊娠中期以降は、さすがにいいことばかりではないのです。
もくじ
貧血がもたらす症状と問題点
赤血球にあるヘモグロビンは、肺から受けとった酸素や、体内でいらなくなった二酸化炭素を運搬する大切な役割をになっています。
貧血によって、血液中のヘモグロビンの濃度がさがると、酸素が身体のすみずみにいきわたらなくなって、動悸や息切れが起きやすくなるのです。頭痛やめまい、発熱、むくみなどの症状があらわれることもあるンです。
こんな症状を「鉄欠乏性貧血」と呼びます。妊娠中の鉄欠乏性貧血は、次のようなトラブルの火種になる恐れだってあるのです。
- 妊娠中毒症
- 陣痛微弱
- お産の出血が増える
- お産で大量出血した際のダメージの増加
- 産褥(さんじょく)感染
- 産後の体力の回復が遅れる
- おっぱいの出が悪くなる
赤ちゃんの発育に悪影響がある、という心配はありません。でも、育児は体力勝負。赤ちゃんが生まれたあと、元気ハツラツで子育てをするためには、妊娠中に毎日しっかりと鉄分をおぎなって、肝臓に十分な量の鉄分を貯蔵しておくことが大事なのです。
予防するには?
鉄分は、意識的に摂取しないと不足しがちなミネラル。成人女性の必要摂取量は1日12mg。ところが、妊婦さんの鉄分の必要量は前半期で15mg、後半期だと20mgまでアップします。
鉄分は、動物性食品に含まれる「ヘム鉄」と、植物性食品に含まれる「非ヘム鉄」の2種に分かれます。おすすめは、ヘム鉄。吸収しやすいからです。豚や鶏のレバーに多く含まれますので、週1くらいでレバニラ炒めを食べるようにするとグーですね。
ほうれん草や小松菜などに含まれている非ヘム鉄は、ヘム鉄ほど吸収はよくないのですけれど、ビタミンを同時に摂取できますので、できたら毎日食べるといいと思います。
鉄分が豊富な食べ物には、こんなものがあります。
- レバー(豚、鶏)
- 赤身の肉類
- まぐろ、かつお、さんま、いわし、わかさぎ
- あさり、牡蠣
- ひじきなど海藻類
- 高野豆腐など大豆食品
- ほうれん草、小松菜
- プルーン
ビタミンCやクエン酸、お酢なんかといっしょに食べると、鉄分が腸で溶けだしやすくなり、吸収率があがるそうです。以下の栄養素は、鉄分の吸収を助けてくれることがわかっています。
- ビタミンC:野菜や柑橘類に多く含まれる。
- ビタミンB2:乳製品、納豆、干ししいたけに多い。
- ビタミンB6:魚介類、乳製品、レバー、卵、とうもろこしに多い。
- ビタミンB12:レバーやさば、乳製品、海藻類に多い。
- 葉酸:アスパラガス、ブロッコリー、レバー、きのこ類に多い。
- たんぱく質:お肉、乳製品、卵、魚介類、大豆食品に多い。
ちなみに、鉄分は、お茶や紅茶、ウーロン茶と同時に摂るのはNGです。渋味成分タンニンが鉄分の吸収を邪魔しますからね。食後30分くらいはお茶を飲むのはやめておきましょう(‐_‐)σ
妊娠中、わたしは次のような食生活を心がけていました。
レバーを食べる



風味にクセがあるので、苦手な方もおられますが、湯通ししてから調理すれば、くさみが抜けて絶品♬
妊娠3か月までは、レバーの食べすぎにご注意ください。大量のビタミンAが含まれています。ビタミンAは、胎児の小耳症や口蓋裂の発症頻度を高めるといわれています。
写真/ニラ醤作って、お手軽ニラレバ炒め! #jisui / kimishowota
たんぱく質を多く摂る



血液の材料になるだけでなく、鉄分の吸収率を高めてくれる働きもあるのです。
ビタミンB群とビタミンCを摂取する



ビタミンB2、B6、B12ビタミンCには、鉄分の吸収を促進する作用があります。
ビタミンB2は納豆、干し椎茸、ビタミンB6はとうもろこし、レバー、魚介類、ビタミンB12は海藻、魚介類、レバー、ビタミンCは新鮮なお野菜、果物にたくさん含まれています。
腸内環境をすこやかに保つ
食生活が不規則だったり、間食や夜食を食べすぎたり、食前に水分を摂りすぎたりしていると、胃腸の働きが低下して、鉄分の吸収がうまくいかなくなります。
健康に腸内環境を維持するため、乳酸菌サプリメントやオリゴ糖を利用するのもいいかも。
なにをしても、貧血がおさまらない場合は?
動悸、息切れ、頭痛、めまい、発熱、むくみ――毎日がんばって鉄分を摂るようにしていてもこんな症状があらわれたときは医師の診察を受けましょう。
定期健診でヘモグロビン濃度が低いとわかった場合もですが、鉄剤(増血剤)を処方されます。お医者さまの指示どおり、きちんと服用しましょう。鉄剤に含まれる成分は、食事で摂取するヘム鉄と同じものですから、妊娠中でも心配はありません。
ウンチがまっ黒になって、びっくりされるママもいますが、余分な鉄分が溶けだしているだけですので、心配は無用。たまに胃がむかむかする方がおられるようですが、鉄剤にもいくつか種類がありますから、お医者さまと相談して、ほかの鉄剤に変えてもらうこともできます。
ちなみに、貧血があまりにひどいケースでは、静脈注射を打つこともあるそうです。



